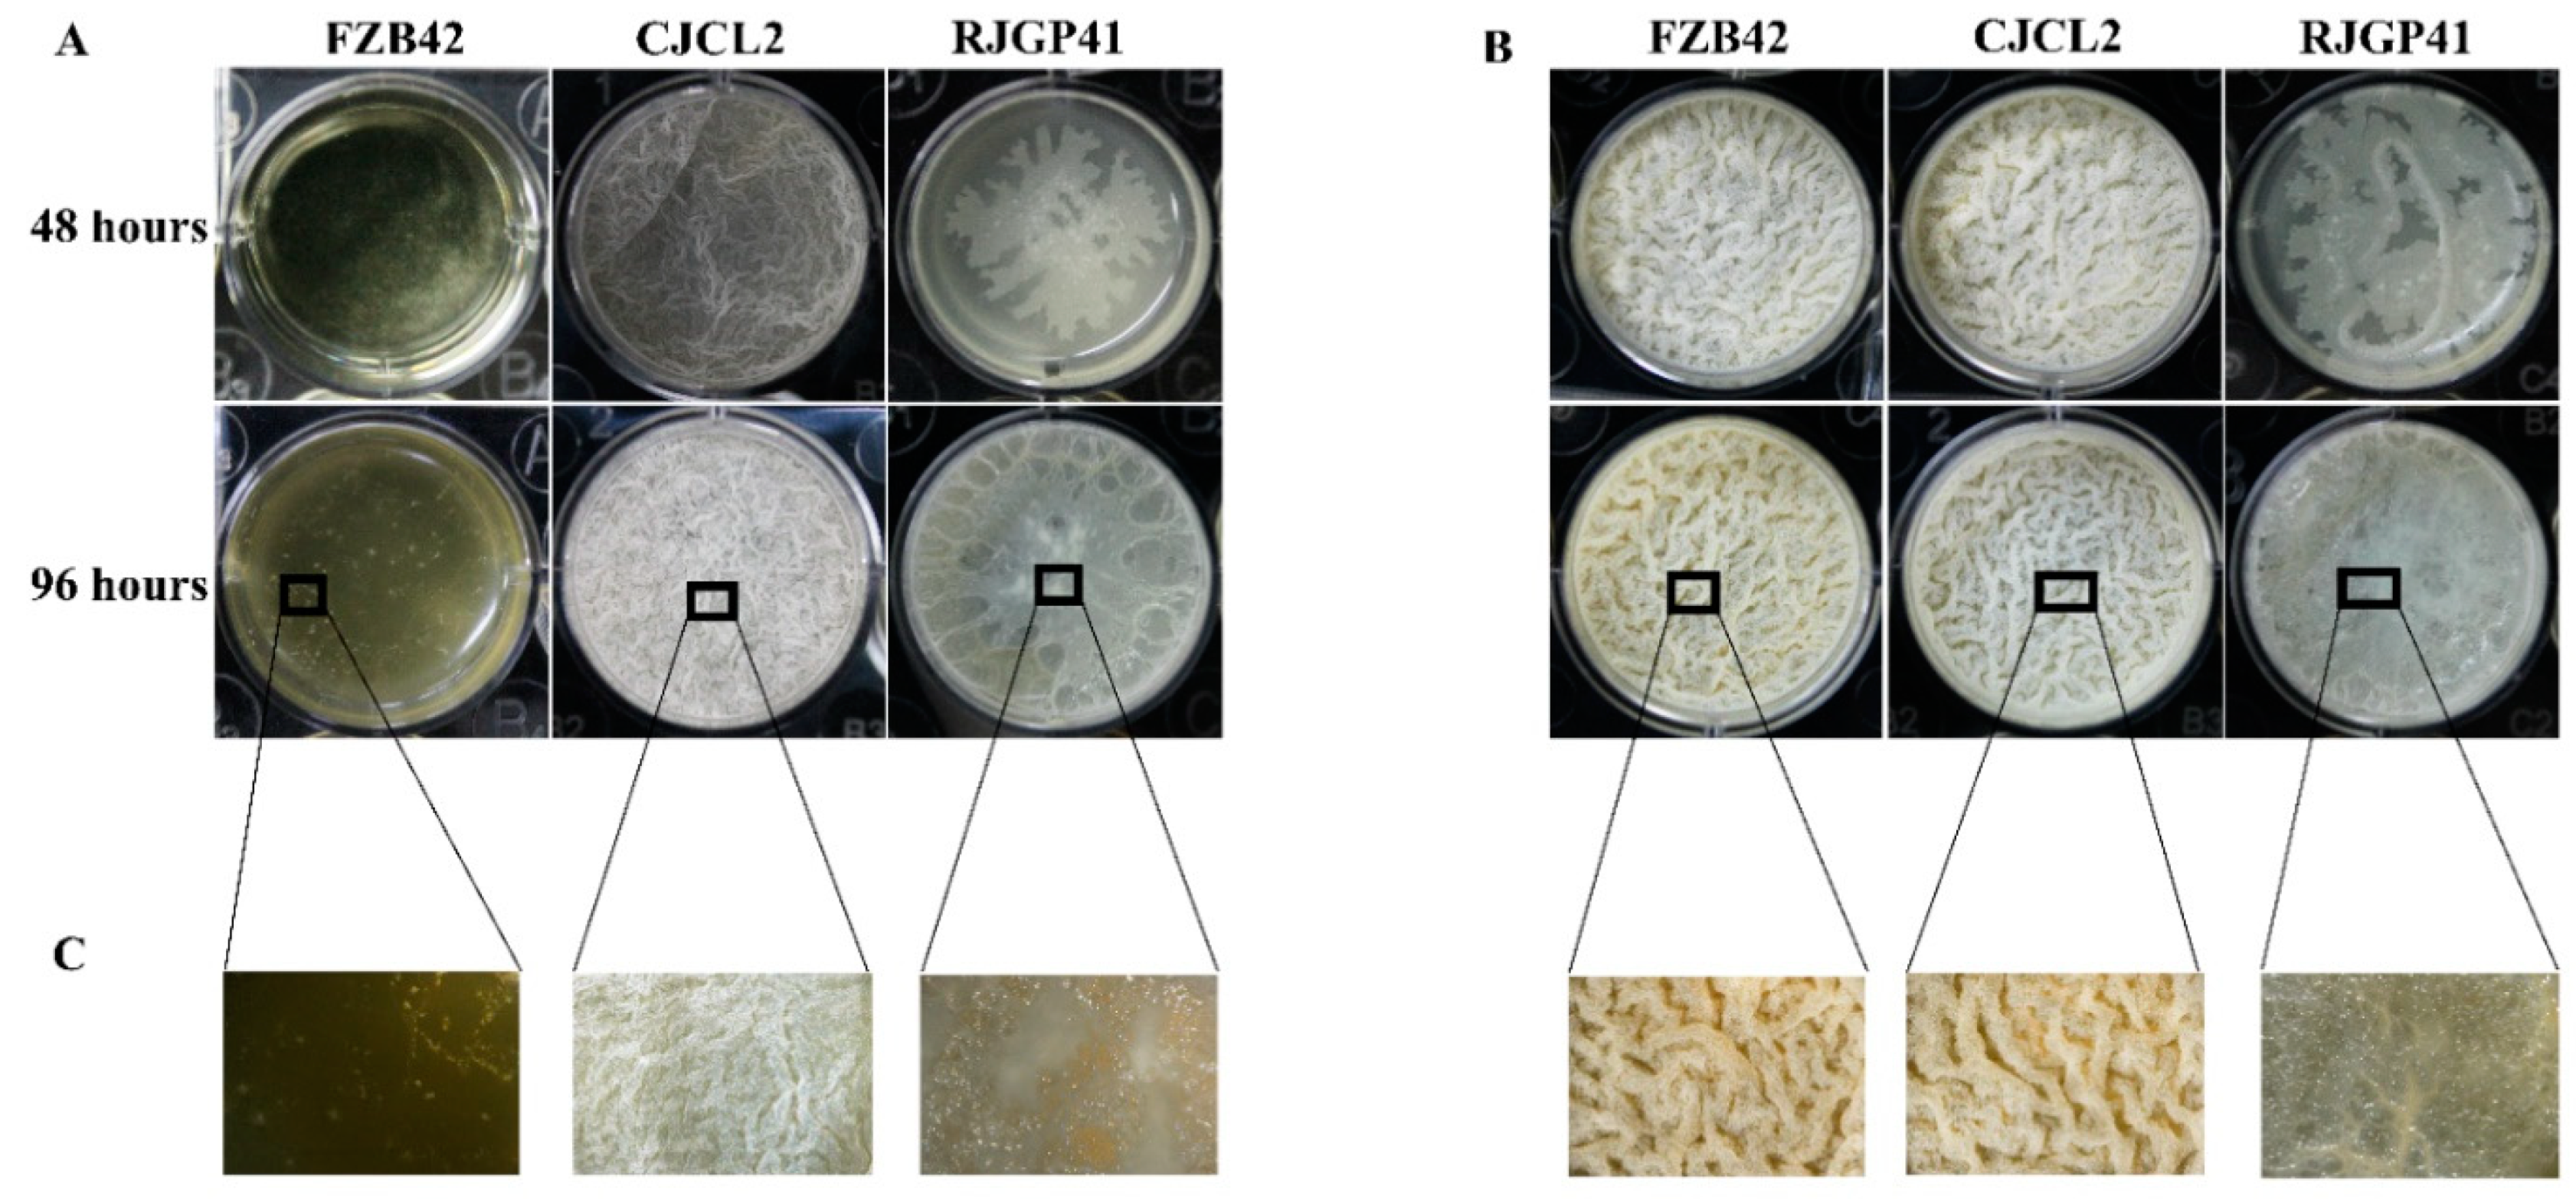
Microorganisms 07 00337 g005

Genetic Screening and Expression Analysis of Psychrophilic Bacillus spp. Reveal Their Potential to Alleviate Cold Stress and Modulate Phytohormones in Wheat
Abstract
1. Introduction
2. Materials and Methods
2.1. Bacterial Growth Screening and Time-Frame Study for Cold-Adaptive Strains
2.2. Extraction of Total Genomic DNA
2.3. Detection of Genes Involved in Cold Tolerance
2.4. RNA Extraction and cDNA Synthesis
2.5. Expression Profiling of Bacterial Genes Influencing Cold Stress Tolerance by qPCR
2.6. ROS Production in Bacillus spp. Under Cold Stress
2.7. Bacterial Biofilm Formation Studies Under Cold Stress
2.8. Molecular detection of PGP traits in Bacteria
2.9. Effect of Cold stress on Vigour Index of Wheat seedlings
2.10. Seedling Root morphology studies under cold stress
2.11. Quantification and Expression Profiling of Plant Stress Response Parameters
2.11.1. Abscisic Acid
2.11.2. Lipid Peroxidation
2.11.3. Proline Accumulation
2.11.4. Expression Analysis of Stress Responsive Genes in Plants
2.12. Effect of Bacterial Isolates on Photosynthetic Potential of Plants Under Cold Stress
2.13. In Planta Growth Promotion Under Cold Stress by Inoculated Bacteria
2.14. Plant Root Morphological Studies by Rhizoscanning
2.15. Expression Profiling of Growth Related Genes in Plants Under Cold Stress
2.16. Quantitative PCR for Expression Studies in Plants
2.17. Statistical Analysis
3. Results
3.1. Bacterial Growth Screening and Time-Frame Study for COLD-Adaptive Strains
3.2. Detection of Genes Involved in Cold Tolerance
3.3. Expression Profiling of Genes Influencing Cold Stress Tolerance by Q-PCR
3.4. ROS Production in Bacillus spp. Under Cold Stress
3.5. Bacterial Biofilm Formation Studies Under Cold Stress
3.6. Molecular detection of PGP traits in Bacteria
3.7. Improvment in Seedling Growth and Root Morphological Parameters Under Cold Stress
3.8. Quantification and Expression Profiling of Plant Stress Response Parameters
3.8.1. Abscisic Acid
3.8.2. Lipid peroxidation
3.8.3. Proline Accumulation
3.8.4. Expression Profiling
3.9. Effect of Bacterial Isolates on Photosynthetic Potential of Plants Under Cold Stress
3.10. In Planta Growth Promotion Under Cold Stress by Inoculated Bacteria
3.11. Expression Profiling of Growth Related Genes in Plants Under Cold Stress
4. Discussion
Supplementary Materials
Author Contributions
Funding
Conflicts of Interest
References
- Tian, X.; He, M.; Wang, Z.; Zhang, J.; Song, Y.; He, Z.; Dong, Y. Application of nitric oxide and calcium nitrate enhances tolerance of wheat seedlings to salt stress. Plant Growth Regul. 2015, 77, 343–356. [Google Scholar] [CrossRef]
- Mahalingam, R. Consideration of combined stress: A crucial paradigm for improving multiple stress tolerance in plants. In Combined Stresses in Plants; Springer: Berlin, Germnay, 2015; pp. 1–25. [Google Scholar]
- Guy, C.; Kaplan, F.; Kopka, J.; Selbig, J.; Hincha, D.K. Metabolomics of temperature stress. Physiol. Plant. 2008, 132, 220–235. [Google Scholar] [CrossRef] [PubMed]
- Egamberdieva, D.; Wirth, S.J.; Alqarawi, A.A.; Abd_Allah, E.F.; Hashem, A. Phytohormones and Beneficial Microbes: Essential Components for Plants to Balance Stress and Fitness. Front. Microbiol. 2017, 8, 2104. [Google Scholar] [CrossRef] [PubMed]
- Mantri, N.; Patade, V.; Penna, S.; Ford, R.; Pang, E. Abiotic stress responses in plants: Present and future. In Abiotic Stress Responses in Plants; Springer: Berlin, Germany, 2012; pp. 1–19. [Google Scholar]
- Bharti, N.; Barnawal, D.; Awasthi, A.; Yadav, A.; Kalra, A. Plant growth promoting rhizobacteria alleviate salinity induced negative effects on growth, oil content and physiological status in Mentha arvensis. Acta Physiol. Plant. 2014, 36, 45–60. [Google Scholar] [CrossRef]
- Bashan, Y.; Holguin, G.; De-Bashan, L.E. Azospirillum-plant relationships: Physiological, molecular, agricultural, and environmental advances (1997–2003). Can. J. Microbiol. 2004, 50, 521–577. [Google Scholar] [CrossRef]
- Selvakumar, G.; Mohan, M.; Kundu, S.; Gupta, A.; Joshi, P.; Nazim, S.; Gupta, H. Cold tolerance and plant growth promotion potential of Serratia marcescens strain SRM (MTCC 8708) isolated from flowers of summer squash (Cucurbita pepo). Lett. Appl. Microbiol. 2008, 46, 171–175. [Google Scholar] [CrossRef] [PubMed]
- Wu, L.; Wu, H.-J.; Qiao, J.; Gao, X.; Borriss, R. Novel routes for improving biocontrol activity of Bacillus based bioinoculants. Front. Microbiol. 2015, 6, 1395. [Google Scholar] [CrossRef]
- Liu, Y.; Chen, L.; Zhang, N.; Li, Z.; Zhang, G.; Xu, Y.; Shen, Q.; Zhang, R. Plant-microbe communication enhances auxin biosynthesis by a root-associated bacterium, Bacillus amyloliquefaciens SQR9. Mol. Plant-Microbe Interact. 2016, 29, 324–330. [Google Scholar] [CrossRef] [PubMed]
- Nicholson, W. Roles of Bacillus endospores in the environment. Cell. Mol. Life Sci. Cmls 2002, 59, 410–416. [Google Scholar] [CrossRef]
- Borriss, R.; Chen, X.-H.; Rueckert, C.; Blom, J.; Becker, A.; Baumgarth, B.; Fan, B.; Pukall, R.; Schumann, P.; Spröer, C. Relationship of Bacillus amyloliquefaciens clades associated with strains DSM 7T and FZB42T: A proposal for Bacillus amyloliquefaciens subsp. amyloliquefaciens subsp. nov. and Bacillus amyloliquefaciens subsp. plantarum subsp. nov. based on complete genome sequence comparisons. Int. J. Syst. Evol. Microbiol. 2011, 61, 1786–1801. [Google Scholar]
- Fan, B.; Wang, C.; Ding, X.L.; Song, X.; Wu, L.; Wu, H.; Xuewen, G.; Borriss, R. Corrigendum: Bacillus velezensis FZB42 in 2018: The Gram-Positive Model Strain for Plant Growth Promotion and Biocontrol. Front. Microbiol. 2019, 10, 1279. [Google Scholar] [CrossRef] [PubMed]
- Calvo, P.; Ormeño-Orrillo, E.; Martínez-Romero, E.; Zúñiga, D. Characterization of Bacillus isolates of potato rhizosphere from andean soils of Peru and their potential PGPR characteristics. Braz. J. Microbiol. 2010, 41, 899–906. [Google Scholar] [CrossRef] [PubMed]
- Yadav, A.N.; Sachan, S.G.; Verma, P.; Saxena, A.K. Bioprospecting of plant growth promoting psychrotrophic Bacilli from the cold desert of north western Indian Himalayas. NISCAIR-CSIR 2016, 54, 142–150. [Google Scholar]
- Ranea, J.A.; Buchan, D.W.; Thornton, J.M.; Orengo, C.A. Evolution of protein superfamilies and bacterial genome size. J. Mol. Biol. 2004, 336, 871–887. [Google Scholar] [CrossRef] [PubMed]
- Dsouza, M.; Taylor, M.W.; Turner, S.J.; Aislabie, J. Genome-based comparative analyses of Antarctic and temperate species of Paenibacillus. Plos One 2014, 9, e108009. [Google Scholar] [CrossRef] [PubMed]
- Kaan, T.; Homuth, G.; Mäder, U.; Bandow, J.; Schweder, T. Genome-wide transcriptional profiling of the Bacillus subtilis cold-shock response. Microbiology 2002, 148, 3441–3455. [Google Scholar] [CrossRef] [PubMed]
- Aguilar, P.S.; Hernandez-Arriaga, A.M.; Cybulski, L.E.; Erazo, A.C.; de Mendoza, D. Molecular basis of thermosensing: A two-component signal transduction thermometer in Bacillus subtilis. Embo J. 2001, 20, 1681–1691. [Google Scholar] [CrossRef] [PubMed]
- Chattopadhyay, M. Low temperature and oxidative stress. Curr. Sci. Bangalore 2002, 83, 109. [Google Scholar]
- Hoffmann, T.; Boiangiu, C.; Moses, S.; Bremer, E. Responses of Bacillus subtilis to hypotonic challenges: Physiological contributions of mechanosensitive channels to cellular survival. Appl. Environ. Microbiol. 2008, 74, 2454–2460. [Google Scholar] [CrossRef] [PubMed]
- Dsouza, M.; Taylor, M.W.; Ryan, J.; MacKenzie, A.; Lagutin, K.; Anderson, R.F.; Turner, S.J.; Aislabie, J. Paenibacillus darwinianus sp. nov., isolated from gamma-irradiated Antarctic soil. Int. J. Syst. Evol. Microbiol. 2014, 64, 1406–1411. [Google Scholar] [CrossRef]
- Yan, F.; Yu, Y.; Gozzi, K.; Chen, Y.; Guo, J.-h.; Chai, Y. Genome-wide investigation of biofilm formation in Bacillus cereus. Appl. Environ. Microbiol. 2017, 83, e00561-17. [Google Scholar] [CrossRef] [PubMed]
- Großkinsky, D.K.; Graaff, E.V.D.; Roitsch, T. Regulation of Abiotic and Biotic Stress Responses by Plant Hormones. Springer 2016, 32, 943. [Google Scholar]
- Kundan, R.; Pant, G.; Jadon, N.; Agrawal, P. Plant growth promoting rhizobacteria: Mechanism and current prospective. J. Fertil Pestic 2015, 6, 9. [Google Scholar] [CrossRef]
- Cutler, S.R.; Rodriguez, P.L.; Finkelstein, R.R.; Abrams, S.R. Abscisic acid: Emergence of a core signaling network. Annu. Rev. Plant Biol. 2010, 61, 651–679. [Google Scholar] [CrossRef] [PubMed]
- Bharti, N.; Barnawal, D.; Wasnik, K.; Tewari, S.K.; Kalra, A. Co-inoculation of Dietzia natronolimnaea and Glomus intraradices with vermicompost positively influences Ocimum basilicum growth and resident microbial community structure in salt affected low fertility soils. Appl. Soil Ecol. 2016, 100, 211–225. [Google Scholar] [CrossRef]
- Gill, S.S.; Tuteja, N. Reactive oxygen species and antioxidant machinery in abiotic stress tolerance in crop plants. Plant Physiol. Biochem. 2010, 48, 909–930. [Google Scholar] [CrossRef]
- Srivastava, S.; Bist, V.; Srivastava, S.; Singh, P.C.; Trivedi, P.K.; Asif, M.H.; Chauhan, P.S.; Nautiyal, C.S. Unraveling aspects of Bacillus amyloliquefaciens mediated enhanced production of rice under biotic stress of Rhizoctonia solani. Front. Plant Sci. 2016, 7, 587. [Google Scholar] [CrossRef]
- Tavakoli, M.; Poustini, K.; Alizadeh, H. Proline Accumulation and Related Genes in Wheat Leav es under Salinity Stress. J. Agr. Sci. Tech. 2018, 18, 707–716. [Google Scholar]
- Bruto, M.; Prigent-Combaret, C.; Muller, D.; Moënne-Loccoz, Y. Analysis of genes contributing to plant-beneficial functions in plant growth-promoting rhizobacteria and related Proteobacteria. Sci. Rep. 2014, 4, 6261. [Google Scholar] [CrossRef]
- Shahzad, R.; Waqas, M.; Khan, A.L.; Asaf, S.; Khan, M.A.; Kang, S.-M.; Yun, B.-W.; Lee, I.-J. Seed-borne endophytic Bacillus amyloliquefaciens RWL-1 produces gibberellins and regulates endogenous phytohormones of Oryza sativa. Plant Physiol. Biochem. 2016, 106, 236–243. [Google Scholar] [CrossRef]
- Bernardr, G.; Cheng, Z.; Jennifer, C.; Jin, D. Promotion of plant growth by ACC deaminase-producing soil bacteria. Eur. J. Plant Pathol. 2007, 119, 329–339. [Google Scholar]
- Naz, I.; Bano, A.; Ul-Hassan, T. Isolation of phytohormones producing plant growth promoting rhizobacteria from weeds growing in Khewra salt range, Pakistan and their implication in providing salt tolerance to Glycine max L. Afr. J. Biotechnol. 2009, 8, 5762–5766. [Google Scholar]
- Lin, Z.; Ni, Z.; Zhang, Y.; Yao, Y.; Wu, H.; Sun, Q. Isolation and characterization of 18 genes encoding α-and β-expansins in wheat (Triticum aestivum L.). Mol. Genet. Genom. 2005, 274, 548–556. [Google Scholar] [CrossRef] [PubMed]
- Kim, Y.C.; Leveau, J.; Gardener, B.B.M.; Pierson, E.A.; Pierson, L.S.; Ryu, C.-M. The multifactorial basis for plant health promotion by plant-associated bacteria. Appl. Environ. Microbiol. 2011, 77, 1548–1555. [Google Scholar] [CrossRef] [PubMed]
- Velho, R.V.; Caldas, D.G.G.; Medina, L.F.C.; Tsai, S.M.; Brandelli, A. Real-time PCR investigation on the expression of sboA and ituD genes in Bacillus spp. Lett. Appl. Microbiol. 2011, 52, 660–666. [Google Scholar] [CrossRef] [PubMed]
- Livak, K.J.; Schmittgen, T.D. Analysis of relative gene expression data using real-time quantitative PCR and the 2−ΔΔCT method. Methods 2001, 25, 402–408. [Google Scholar] [CrossRef] [PubMed]
- Massawe, V.C.; Rao, A.H.; Farzand, A.; Mburu, D.K.; Gao, X. Volatile Organic Compounds of Endophytic Bacillus spp. have Biocontrol Activity Against Sclerotinia sclerotiorum. Phytopathology 2018, 108. [Google Scholar]
- Gingichashvili, S.; Duanis-Assaf, D.; Shemesh, M.; Featherstone, J.D.B.; Feuerstein, O.; Steinberg, D. Bacillus subtilisBiofilm Development – A Computerized Study of Morphology and Kinetics. Front. Microbiol. 2017, 8, 2072. [Google Scholar] [CrossRef]
- Janette, O.L.; Ismael, H.L.; Lourdes, G.; Jesús, C.M. ACC (1-aminocyclopropane-1-carboxylate) deaminase activity, a widespread trait in Burkholderia species, and its growth-promoting effect on tomato plants. Appl. Environ. Microbiol. 2009, 75, 6581. [Google Scholar]
- Kang, S.-M.; Shahzad, R.; Bilal, S.; Khan, A.L.; Park, Y.-G.; Lee, K.-E.; Asaf, S.; Khan, M.A.; Lee, I.-J. Indole-3-acetic-acid and ACC deaminase producing Leclercia adecarboxylata MO1 improves Solanum lycopersicum L. growth and salinity stress tolerance by endogenous secondary metabolites regulation. BMC Microbiol. 2019, 19, 80. [Google Scholar] [CrossRef]
- Suleman, M.; Yasmin, S.; Rasul, M.; Yahya, M.; Mirza, M.S. Phosphate solubilizing bacteria with glucose dehydrogenase gene for phosphorus uptake and beneficial effects on wheat. PLoS ONE 2018, 13, e0204408. [Google Scholar] [CrossRef] [PubMed]
- Rasul, M.; Yasmin, S.; Zubair, M.; Mahreen, N.; Yousaf, S.; Arif, M.; Sajid, Z.I.; Mirza, M.S. Phosphate solubilizers as antagonists for bacterial leaf blight with improved rice growth in phosphorus deficit soil. Biol. Control 2019, 136, 103997. [Google Scholar] [CrossRef]
- Li, D.; Xu, G.; Ren, G.; Sun, Y.; Huang, Y.; Liu, C. The Application of Ultra-High-Performance Liquid Chromatography Coupled with a LTQ-Orbitrap Mass Technique to Reveal the Dynamic Accumulation of Secondary Metabolites in Licorice under ABA Stress. Molecules 2017, 22, 1742. [Google Scholar] [CrossRef] [PubMed]
- Pavlović, I.; Petřík, I.; Tarkowská, D.; Lepeduš, H.; Vujčić Bok, V.; Radić Brkanac, S.; Novák, O.; Salopek-Sondi, B. Correlations between Phytohormones and Drought Tolerance in Selected Brassica Crops: Chinese Cabbage, White Cabbage and Kale. Int. J. Mol. Sci. 2018, 19, 2866. [Google Scholar] [CrossRef] [PubMed]
- Tiwari, S.; Prasad, V.; Chauhan, P.S.; Lata, C. Bacillus amyloliquefaciens confers tolerance to various abiotic stresses and modulates plant response to phytohormones through osmoprotection and gene expression regulation in rice. Front. Plant Sci. 2017, 8, 1510. [Google Scholar] [CrossRef] [PubMed]
- Liu, W.; Yu, K.; He, T.; Li, F.; Zhang, D.; Liu, J. The low temperature induced physiological responses of Avena nuda L., a cold-tolerant plant species. Sci. World J. 2013, 2013. [Google Scholar]
- Tahir, H.A.S.; Gu, Q.; Wu, H.; Raza, W.; Hanif, A.; Wu, L.; Colman, M.V.; Gao, X. Plant Growth Promotion by Volatile Organic Compounds Produced by Bacillus subtilis SYST2. Front. Microbiol. 2017, 8. [Google Scholar] [CrossRef]
- Sikand, K.; Singh, J.; Ebron, J.S.; Shukla, G.C. Housekeeping gene selection advisory: Glyceraldehyde-3-phosphate dehydrogenase (GAPDH) and β-actin are targets of miR-644a. PLoS ONE 2012, 7, e47510. [Google Scholar] [CrossRef] [PubMed]
- Lata, C.; Jha, S.; Dixit, V.; Sreenivasulu, N.; Prasad, M. Differential antioxidative responses to dehydration-induced oxidative stress in core set of foxtail millet cultivars [Setaria italica (L.)]. Protoplasma 2011, 248, 817–828. [Google Scholar] [CrossRef]
- Glick, B.R. Bacteria with ACC deaminase can promote plant growth and help to feed the world. Microbiol. Res. 2014, 169, 30–39. [Google Scholar] [CrossRef]
- García, J.E.; Maroniche, G.; Creus, C.; Suárez-Rodríguez, R.; Ramirez-Trujillo, J.A.; Groppa, M.D. In vitro PGPR properties and osmotic tolerance of different Azospirillum native strains and their effects on growth of maize under drought stress. Microbiol. Res. 2017, 202, 21–29. [Google Scholar] [CrossRef] [PubMed]
- Gagné-Bourque, F.; Mayer, B.F.; Charron, J.-B.; Vali, H.; Bertrand, A.; Jabaji, S. Accelerated growth rate and increased drought stress resilience of the model grass Brachypodium distachyon colonized by Bacillus subtilis B26. PLoS ONE 2015, 10, e0130456. [Google Scholar] [CrossRef] [PubMed]
- Allen, M.A.; Lauro, F.M.; Williams, T.J.; Burg, D.; Siddiqui, K.S.; De Francisci, D.; Chong, K.W.; Pilak, O.; Chew, H.H.; De Maere, M.Z. The genome sequence of the psychrophilic archaeon, Methanococcoides burtonii: The role of genome evolution in cold adaptation. ISME J. 2009, 3, 1012. [Google Scholar] [CrossRef]
- Kempf, B.; Bremer, E. OpuA, an osmotically regulated binding protein-dependent transport system for the osmoprotectant glycine betaine in Bacillus subtilis. J. Biol. Chem. 1995, 270, 16701–16713. [Google Scholar] [CrossRef] [PubMed]
- Wolf, D.; Rippa, V.; Mobarec, J.C.; Sauer, P.; Adlung, L.; Kolb, P.; Bischofs, I.B. The quorum-sensing regulator ComA from Bacillus subtilis activates transcription using topologically distinct DNA motifs. Nucleic Acids Res. 2016, 44, 2160–2172. [Google Scholar] [CrossRef] [PubMed]
- Kaan, T.; Jürgen, B.; Schweder, T. Regulation of the expression of the cold shock proteins CspB and CspC in Bacillus subtilis. Mol. Gen. Genet. MGG 1999, 262, 351. [Google Scholar] [CrossRef]
- Graumann, P.L.; Marahiel, M.A. Cold shock response in Bacillus subtilis. J. Mol. Microbiol. Biotechnol. 1999, 1, 203. [Google Scholar] [PubMed]
- Dogsa, I.; Choudhary, K.S.; Marsetic, Z.; Hudaiberdiev, S.; Vera, R.; Pongor, S.; Mandicmulec, I. ComQXPA quorum sensing systems may not be unique to Bacillus subtilis: A census in prokaryotic genomes. PLoS ONE 2014, 9, e96122. [Google Scholar] [CrossRef] [PubMed]
- Sun, G.; Birkey, S.M.; Hulett, F.M. Three two-component signal-transduction systems interact for Pho regulation in Bacillus subtilis. Mol. Microbiol. 2010, 19, 941–948. [Google Scholar] [CrossRef] [PubMed]
- Helmann, J.D.; Wu, M.F.; Gaballa, A.; Kobel, P.A.; Morshedi, M.M.; Fawcett, P.; Paddon, C. The global transcriptional response of Bacillus subtilis to peroxide stress is coordinated by three transcription factors. J. Bacteriol. 2003, 185, 243. [Google Scholar] [CrossRef] [PubMed]
- Cadenas, E.; Davies, K.J. Mitochondrial free radical generation, oxidative stress, and aging. Free Radic. Biol. Med. 2000, 29, 222–230. [Google Scholar] [CrossRef]
- Flemming, H.; Wingender, J. The biofilm matrix. Nat Rev Microbiol. 2010, 8, 623–633. [Google Scholar] [CrossRef] [PubMed]
- Feldman, M.; Ginsburg, I.; Al-Quntar, A.; Steinberg, D. Thiazolidinedione-8 alters symbiotic relationship in C. albicans-S. mutans dual species biofilm. Front. Microbiol. 2016, 7, 140. [Google Scholar] [CrossRef] [PubMed]
- Lee, B.-H.; Hébraud, M.; Bernardi, T. Increased adhesion of Listeria monocytogenes strains to abiotic surfaces under cold stress. Front. Microbiol. 2017, 8, 2221. [Google Scholar] [CrossRef] [PubMed]
- Sharma, P.; Jha, A.B.; Dubey, R.S.; Pessarakli, M. Reactive oxygen species, oxidative damage, and antioxidative defense mechanism in plants under stressful conditions. J. Bot. 2012. [Google Scholar] [CrossRef]
- Jain, D.; Chattopadhyay, D. Analysis of gene expression in response to water deficit of chickpea (Cicer arietinum L.) varieties differing in drought tolerance. BMC Plant Biol. 2010, 10, 24. [Google Scholar] [CrossRef] [PubMed]
- Song, S.-Y.; Chen, Y.; Chen, J.; Dai, X.-Y.; Zhang, W.-H. Physiological mechanisms underlying OsNAC5-dependent tolerance of rice plants to abiotic stress. Planta 2011, 234, 331–345. [Google Scholar] [CrossRef] [PubMed]
- Weber, H.; Chételat, A.; Reymond, P.; Farmer, E.E. Selective and powerful stress gene expression in Arabidopsis in response to malondialdehyde. Plant J. 2004, 37, 877–888. [Google Scholar] [CrossRef]
- Adesemoye, A.; Torbert, H.; Kloepper, J. Enhanced plant nutrient use efficiency with PGPR and AMF in an integrated nutrient management system. Can. J. Microbiol. 2008, 54, 876–886. [Google Scholar] [CrossRef]
- Wu, H.; Gu, Q.; Xie, Y.; Lou, Z.; Xue, P.; Fang, L.; Yu, C.; Jia, D.; Huang, G.; Zhu, B. Cold-adapted Bacilli isolated from the Qinghai–Tibetan Plateau are able to promote plant growth in extreme environments. Environ. Microbiol. 2019. [Google Scholar] [CrossRef]
- Ahmad, M.; Zahir, Z.A.; Asghar, H.N.; Asghar, M. Inducing salt tolerance in mung bean through coinoculation with rhizobia and plant-growth-promoting rhizobacteria containing 1-aminocyclopropane-1-carboxylate deaminase. Can. J. Microbiol. 2011, 57, 578–589. [Google Scholar] [CrossRef] [PubMed]
- Ali, S.Z.; Sandhya, V.; Grover, M.; Kishore, N.; Rao, L.V.; Venkateswarlu, B. Pseudomonas sp. strain AKM-P6 enhances tolerance of sorghum seedlings to elevated temperatures. Biol. Fertil. Soils 2009, 46, 45–55. [Google Scholar] [CrossRef]
- Arshad, M.; Shaharoona, B.; Mahmood, T. Inoculation with Pseudomonas spp. containing ACC-deaminase partially eliminates the effects of drought stress on growth, yield, and ripening of pea (Pisum sativum L.). Pedosphere 2008, 18, 611–620. [Google Scholar] [CrossRef]
- Perez, E.; Sulbaran, M.; Ball, M.M.; Yarzabal, L.A. Isolation and characterization of mineral phosphate-solubilizing bacteria naturally colonizing a limonitic crust in the south-eastern Venezuelan region. Soil Biol. Biochem. 2007, 39, 2905–2914. [Google Scholar] [CrossRef]
- Schmülling, T. New insights into the functions of cytokinins in plant development. J. Plant Growth Regul. 2002, 21, 40. [Google Scholar] [PubMed]
- Asgher, M.; Khan, M.I.R.; Anjum, N.A.; Khan, N.A. Minimising toxicity of cadmium in plants—role of plant growth regulators. Protoplasma 2015, 252, 399–413. [Google Scholar] [CrossRef] [PubMed]
- Marowa, P.; Ding, A.; Kong, Y. Expansins: Roles in plant growth and potential applications in crop improvement. Plant Cell Rep. 2016, 35, 949–965. [Google Scholar] [CrossRef] [PubMed]
- Kwon, Y.S.; Ryu, C.-M.; Lee, S.; Park, H.B.; Han, K.S.; Lee, J.H.; Lee, K.; Chung, W.S.; Jeong, M.-J.; Kim, H.K. Proteome analysis of Arabidopsis seedlings exposed to bacterial volatiles. Planta 2010, 232, 1355–1370. [Google Scholar] [CrossRef] [PubMed]
- Brettin, T.; Davis, J.J.; Disz, T.; Edwards, R.A.; Gerdes, S.; Olsen, G.J.; Olson, R.; Overbeek, R.; Parrello, B.; Pusch, G.D.; et al. RASTtk: A modular and extensible implementation of the RAST algorithm for building custom annotation pipelines and annotating batches of genomes. Sci. Rep. 2015, 5, 8365. [Google Scholar] [CrossRef] [PubMed]
- Hayat, R.; Ali, S.; Amara, U.; Khalid, R.; Ahmed, I. Soil beneficial bacteria and their role in plant growth promotion: a review. Ann. Microbiol. 2010, 60, 579–598. [Google Scholar] [CrossRef]

© 2019 by the authors. Licensee MDPI, Basel, Switzerland. This article is an open access article distributed under the terms and conditions of the Creative Commons Attribution (CC BY) license (http://creativecommons.org/licenses/by/4.0/).
Share and Cite
Zubair, M.; Hanif, A.; Farzand, A.; Sheikh, T.M.M.; Khan, A.R.; Suleman, M.; Ayaz, M.; Gao, X. Genetic Screening and Expression Analysis of Psychrophilic Bacillus spp. Reveal Their Potential to Alleviate Cold Stress and Modulate Phytohormones in Wheat. Microorganisms 2019, 7, 337. https://doi.org/10.3390/microorganisms7090337
Zubair M, Hanif A, Farzand A, Sheikh TMM, Khan AR, Suleman M, Ayaz M, Gao X. Genetic Screening and Expression Analysis of Psychrophilic Bacillus spp. Reveal Their Potential to Alleviate Cold Stress and Modulate Phytohormones in Wheat. Microorganisms. 2019; 7(9):337. https://doi.org/10.3390/microorganisms7090337
Chicago/Turabian StyleZubair, Muhammad, Alvina Hanif, Ayaz Farzand, Taha Majid Mahmood Sheikh, Abdur Rashid Khan, Muhammad Suleman, Muhammad Ayaz, and Xuewen Gao. 2019. "Genetic Screening and Expression Analysis of Psychrophilic Bacillus spp. Reveal Their Potential to Alleviate Cold Stress and Modulate Phytohormones in Wheat" Microorganisms 7, no. 9: 337. https://doi.org/10.3390/microorganisms7090337
APA StyleZubair, M., Hanif, A., Farzand, A., Sheikh, T. M. M., Khan, A. R., Suleman, M., Ayaz, M., & Gao, X. (2019). Genetic Screening and Expression Analysis of Psychrophilic Bacillus spp. Reveal Their Potential to Alleviate Cold Stress and Modulate Phytohormones in Wheat. Microorganisms, 7(9), 337. https://doi.org/10.3390/microorganisms7090337

